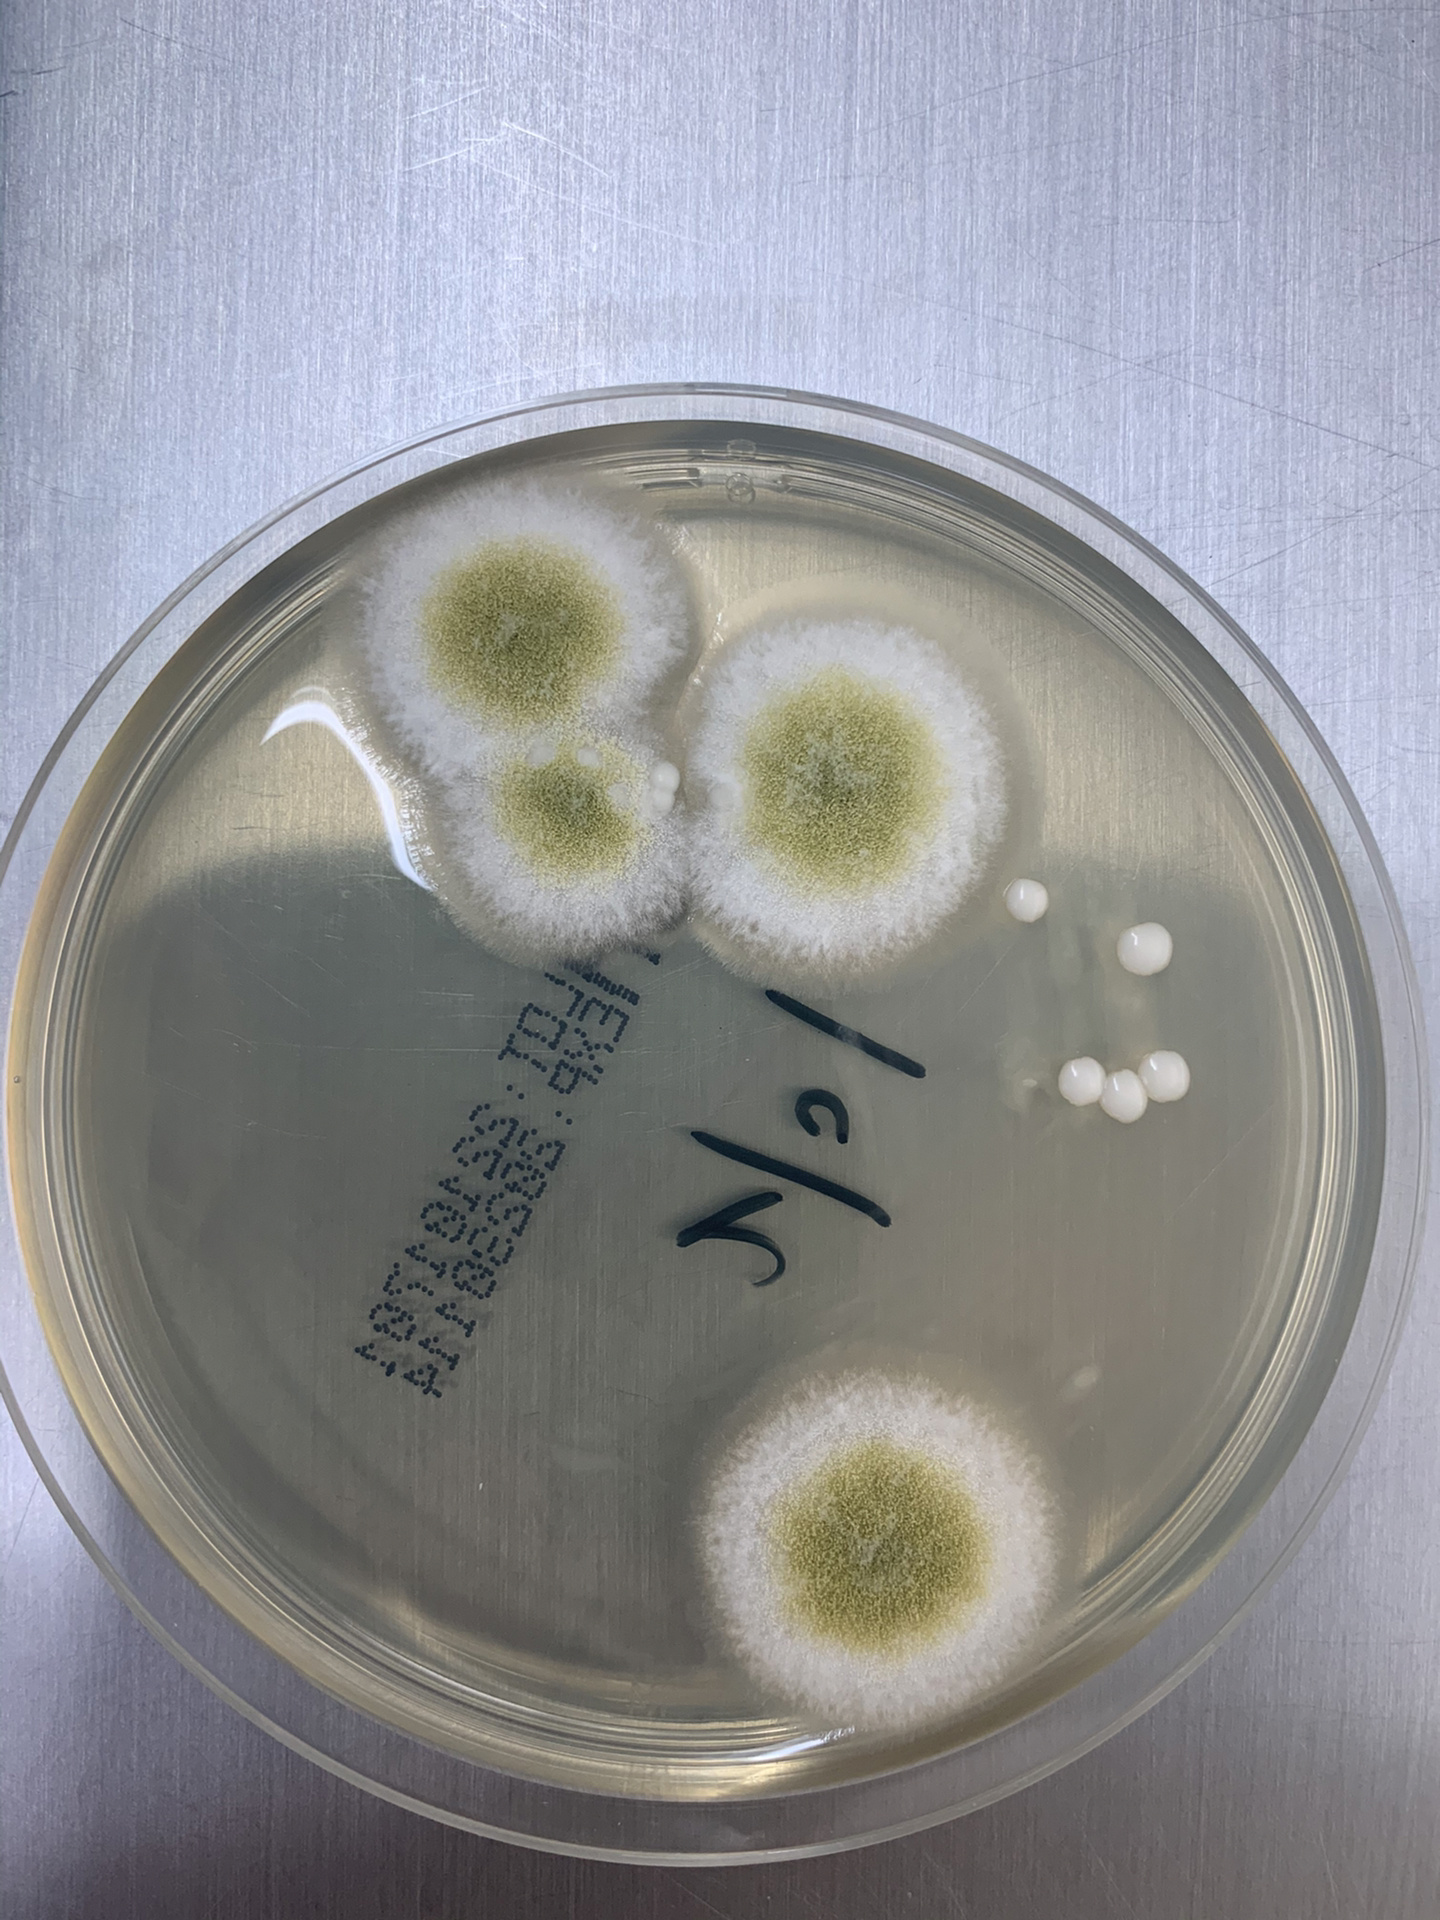
今天给大家分享一组真菌培养及镜下形态图

图片找真菌

分享在进修期间看到的各种真菌形态
图片尺寸961x1280
癣菌显微镜检图片分享
图片尺寸1440x1050
🌿真菌世界:显微镜下的形态之美🔬
图片尺寸1440x1050
分享在进修期间看到的各种真菌形态
图片尺寸960x1280
你呼吸的每一口空气,都在喂养体内的"僵尸真菌"?
图片尺寸1242x828
真菌期
图片尺寸752x670
真菌太可怕
图片尺寸2048x2731
摄影师 barbora batokova
图片尺寸2000x2375
真菌
图片尺寸1595x1600
水生真菌
图片尺寸1076x718
生物学的历史发展
图片尺寸1242x828
分享一组真菌照片,外形独特,仿佛不属于地球的物种
图片尺寸960x1280
一张图告诉你真菌孢子的多样性
图片尺寸1280x1706
今天给大家分享一组真菌培养及镜下形态图
图片尺寸1440x1920 图片尺寸2160x2880
图片尺寸2160x2880
林地真菌
图片尺寸1600x1068
还在为脚气困扰吗?试试这款真菌王套装#真菌王礼盒#脚气#异味
图片尺寸1240x1656
宝子们还在为真菌困扰吗😭 这款香港正品真菌王一定要试试!
图片尺寸2160x2880
的研究人员报告说,这种真菌是叫做耳念珠
图片尺寸2179x1280
真菌照片摄影图片
图片尺寸1599x1600











 图片尺寸2160x2880
图片尺寸2160x2880

图片尺寸2160x2880
图片尺寸2160x2880



